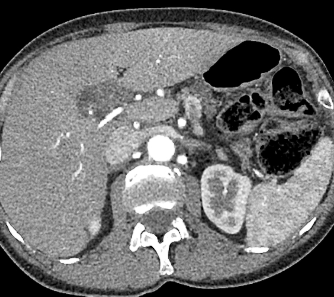

Abdome: doença hepática difusa
Depósito de gordura.
Espectro de evolução?
Esteatose –> Esteatohepatite (NASH) –> Cirrose.

Abdome: doença hepática difusa
Depósito de gordura
V ou F?
A NASH está ligada a obesidade.
Verdadeiro.
(15-20% dos obesos, DM-2 e hiperlipidemia.)
Abdome: doença hepática difusa
Depósito de gordura
V ou F?
A NASH é irreversível.
Falso.
A NASH é reversível, porém seu próximo espectro, a cirrose, é irreversível.
Abdome: doença hepática difusa
Depósito de gordura
V ou F?
O exame histopatológico é o método referência para diagnóstico e gradução.
Verdadeiro.

Porém, é um método invasivo e pouco prático, impraticável na monitorização.
Abdome: doença hepática difusa
Depósito de gordura
V ou F?
A quimioterapia no geral não está associada à doença hepática gordurosa não alcoólica (DHGNA).
Falso.

A quimioterapia é um fator de indução da DHGNA.
Abdome: doença hepática difusa
Depósito de gordura
Fatores de confusão do diagnóstico ao USG? (3)
- A avaliação qualitativa é feita de forma subjetiva;
- O parênquima a ser comparado alterado (ex: fibrose renal);
- Lesões focais hepáticas podem confundir.

Abdome: doença hepática difusa
Depósito de gordura
Referências para comparação/graduação da ecogenicidade hepática ao USG? (4)
- Parênquima renal;
- Parênquima esplênico;
- Vasos intra-hepáticos;
- Diafragma.

Abdome: doença hepática difusa
Depósito de gordura
V ou F?
Na TC a avaliação é feita na fase pré-contraste. Avalia-se objetivamente através do valor absoluto e comparativo do ROI (diferença >5 entre fígado e baço) e subjetivamente através da visualização dos vasos.
Verdadeiro.

Abdome: doença hepática difusa
Depósito de gordura
V ou F?
A RM é o método mais sensível para detecção e caracterização.
Verdadeiro.

Abdome: doença hepática difusa
Depósito de gordura
V ou F?
A coexistência de sobrecarga férrica não atrapalha o diagnóstico.
Falso.
A coexistência de sobrecarga férrica
falseia o diagnóstico.
Abdome: doença hepática difusa
Depósito de gordura
Padrões possíveis? (7)
- Difuso;
- Distribuição heterogênea;
- Esteatose focal;
- Área poupada de esteatose;
- Multifocal / multinodular;
- Perivascular;
- Subcapsular.

Abdome: doença hepática difusa
V ou F?
A lesão hipoatenuante próxima ao hilo hepático corresponde a um nódulo a ser esclarecido.
Falso.
A lesão hipoatenuante próxima ao hilo hepático corresponde a área poupada de esteatose.
Abdome: doença hepática difusa
Locais característicos de pseudolesão devido à área poupada de esteatose? (4)
- Adjacente à porta hepatis (segmento 4);
- Fossa da vesícula biliar;
- Adjacente ao ligamento falciforme;
- Parênquima subcapsular.

Abdome: doença hepática difusa
V ou F?
As lesões focais hepáticas na imagem são suspeitas para metástases.

Falso.
As lesões na imagem correspondem a esteatose multifocal/multinodular.
Abdome: doença hepática difusa
Aspectos importantes na diferenciação de depósito de gordura para lesões nodulares focais verdadeiras? (5)
- Topografias típicas;
- Não ocupa espaço no parênquima hepático;
- Não exerce efeito de massa;
- Não desvia estruturas vasculares;
- Preserva o contorno hepático.

Abdome: doença hepática difusa
Depósito de ferro
V ou F?
O espectro da doença possue sintomas, sinais e laboratório inespecífico.
Verdadeiro.
Por isso o diagnóstico geralmente é tardio. O aumento de ferritina e saturação de transferrina não é específico.
Abdome: doença hepática difusa
Depósito de ferro
V ou F?
Na hemocromatose primária, o acúmulo de ferro ocorre devido a uma condição genética, enquanto na forma secundária resulta de fatores externos, como transfusões ou dieta.
Verdadeiro.
Abdome: doença hepática difusa
Depósito de ferro
A hemocromatose primária afeta ____________( múltiplos órgãos/fígado e baço), enquanto a secundária afeta ___________ (múltiplos órgãos/fígado e baço).
Múltiplos órgãos/fígado e baço.
A primária afeta fígado, pâncreas, hipófise, tireoide e coração, enquanto a secundária afeta os órgãos do sistema retículo endotelial.
Abdome: doença hepática difusa
Depósito de ferro
O melhor método de avaliação é a __ (TC/RM).
RM.

Na TC o achado de aumento da atenuação é inespecífico, encontrado também em diversas outras doenças (uso de amiodarona, sais de ouro, doença Wilson)
Abdome: doença hepática difusa
Depósito de ferro
Vantagens da RM?
- Confirmação diagnóstica;
- Quantificação da sobrecarga férrica;
- Determinar severidade;
- Monitorar terapia;
- Diferenciar hemocromatose primária e secundária.

Abdome: doença hepática difusa
Depósito de ferro
Achado característico na RM?
Queda de sinal na sequência “em fase” em relação à sequência “fora de fase”.
(Efeito oposto ao observado na esteatose)

Abdome: doença hepática difusa
HD?

Budd-Chiari.
Achados característicos:
Hipertrofia do lobo caudado; atrofia / necrose do parênquima periférico – realce em mosaico; veias colaterais intra-hepáticas; nódulos regenerativos; ascite.
Abdome: doença hepática difusa
Budd-Chiari?
Obstrução da drenagem venosa (veias centro-lobulares, veias hepáticas e VCI), levando a um estado de hipercoagubilidade.

Abdome: doença hepática difusa
Budd-Chiari
Achados de imagem? (6)
- Hipertrofia do lobo caudado;
- Atrofia / necrose do parênquima periférico – realce em mosaico;
- Veias colaterais intra-hepáticas;
- Nódulos regenerativos;
- Ausência de fluxo na VCI;
- Ascite.

























